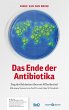
Das Ende der Antibiotika - Bild 1

Das Ende der Antibiotika
Sieg der Bakterien über ein Allheilmittel

PAYBACK Punkte
0 °P sammeln!
Seit einigen Jahren gibt es immer mehr Ausbrüche von multiresistenten Bakterien mit manchmal fatalen Folgen für Patienten. Das Rotterdamer Maasstad Krankenhaus, das Klinikum Bremen Mitte, die Uniklinik Leipzig, sie alle hatten mit ernsthaften Ausbrüchen zu kämpfen. In den Niederlanden kam es zu einer Q-Fieber-Epidemie in bis dahin unbekanntem Ausmaß. Deutschland bekam es mit einem bisher einzigartigen EHEC-Ausbruch zu tun.Lange waren Antibiotika das Wundermittel, das mit bakteriellen Infektionen kurzen Prozess machte und die Sterblichkeit bei Infektionskrankheiten drastisch sinken ließ. ...
Seit einigen Jahren gibt es immer mehr Ausbrüche von multiresistenten Bakterien mit manchmal fatalen Folgen für Patienten. Das Rotterdamer Maasstad Krankenhaus, das Klinikum Bremen Mitte, die Uniklinik Leipzig, sie alle hatten mit ernsthaften Ausbrüchen zu kämpfen. In den Niederlanden kam es zu einer Q-Fieber-Epidemie in bis dahin unbekanntem Ausmaß. Deutschland bekam es mit einem bisher einzigartigen EHEC-Ausbruch zu tun.Lange waren Antibiotika das Wundermittel, das mit bakteriellen Infektionen kurzen Prozess machte und die Sterblichkeit bei Infektionskrankheiten drastisch sinken ließ. Inzwischen wird der Nachteil, der diese einzigartigen Mittel begleitet, immer schwerwiegender. Die Anwendung von Antibiotika führt unvermeidlich zu Resistenzen bei Bakterien und damit zur Unwirksamkeit der Antibiotika.In »Das Ende der Antibiotika« spricht Rinke van den Brink mit einer Auswahl von internationalen Experten und befragt sie nach möglichen Lösungen für das weltweite Problem der Antbiotikaresistenzen. Dabei wird eins sehr deutlich: Für die Bekämpfung von Antibiotikaresistenzen benötigt man einen internationalen Ansatz, wie er beispielsweiseim EurSafety Health-net, dem euregionalen deutsch-niederländischen Netzwerk für Patientensicherheit und Infektionsschutz, umgesetzt wird (www.eursafety.eu).